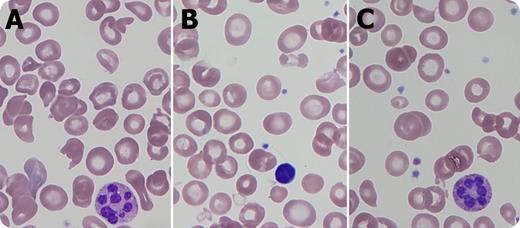
A 7-month-old boy with a history of necrotizing enterocolitis and developmental delay was admitted for anemia (hemoglobin 4.8 g/dL) and thrombocytopenia (platelets 91 × 109/L) with normal white blood cell count (5.4 × 109/L), mean corpuscular volume 90.2 fL, lactate dehydrogenase 757 U/L, and 3+ hemoglobinuria without microscopic hematuria. The blood smear demonstrated hypersegmented neutrophils (panels A,C), macrocytes (panel B), and red blood cell fragments (panels A,C). Serum folate and vitamin B12 were normal, but plasma homocysteine was elevated (>100.0 μmol/L), methionine decreased (10 μmol/L), and methylmalonic acid normal, indicating a specific homocysteine to methionine conversion defect. Fibroblast functional analysis showed reduced 14C methyltetrahydrofolate incorporation, and methionine synthase (MTR) gene sequencing revealed a known pathogenic mutation and a previously unreported mutation affecting splicing. Thus, cobalamin (cbl)G deficiency was diagnosed. / Peripheral blood smear analysis was key in this case, linking microangiopathic hemolytic anemia to a megaloblastic process. This combination of findings is described in pernicious anemia and inborn errors of cobalamin metabolism affecting homocysteine methylation and conversion to methionine, specifically the methylcobalamin deficiencies cblC-G and cblJ. Key considerations in management are betaine and hydroxycobalamin supplementation, as well as thromboprophylaxis for intravascular coagulation attributable to markedly elevated homocysteine levels.

A 7-month-old boy with a history of necrotizing enterocolitis and developmental delay was admitted for anemia (hemoglobin 4.8 g/dL) and thrombocytopenia (platelets 91 × 109/L) with normal white blood cell count (5.4 × 109/L), mean corpuscular volume 90.2 fL, lactate dehydrogenase 757 U/L, and 3+ hemoglobinuria without microscopic hematuria. The blood smear demonstrated hypersegmented neutrophils (panels A,C), macrocytes (panel B), and red blood cell fragments (panels A,C). Serum folate and vitamin B12 were normal, but plasma homocysteine was elevated (>100.0 μmol/L), methionine decreased (10 μmol/L), and methylmalonic acid normal, indicating a specific homocysteine to methionine conversion defect. Fibroblast functional analysis showed reduced 14C methyltetrahydrofolate incorporation, and methionine synthase (MTR) gene sequencing revealed a known pathogenic mutation and a previously unreported mutation affecting splicing. Thus, cobalamin (cbl)G deficiency was diagnosed.
Peripheral blood smear analysis was key in this case, linking microangiopathic hemolytic anemia to a megaloblastic process. This combination of findings is described in pernicious anemia and inborn errors of cobalamin metabolism affecting homocysteine methylation and conversion to methionine, specifically the methylcobalamin deficiencies cblC-G and cblJ. Key considerations in management are betaine and hydroxycobalamin supplementation, as well as thromboprophylaxis for intravascular coagulation attributable to markedly elevated homocysteine levels.
A 7-month-old boy with a history of necrotizing enterocolitis and developmental delay was admitted for anemia (hemoglobin 4.8 g/dL) and thrombocytopenia (platelets 91 × 109/L) with normal white blood cell count (5.4 × 109/L), mean corpuscular volume 90.2 fL, lactate dehydrogenase 757 U/L, and 3+ hemoglobinuria without microscopic hematuria. The blood smear demonstrated hypersegmented neutrophils (panels A,C), macrocytes (panel B), and red blood cell fragments (panels A,C). Serum folate and vitamin B12 were normal, but plasma homocysteine was elevated (>100.0 μmol/L), methionine decreased (10 μmol/L), and methylmalonic acid normal, indicating a specific homocysteine to methionine conversion defect. Fibroblast functional analysis showed reduced 14C methyltetrahydrofolate incorporation, and methionine synthase (MTR) gene sequencing revealed a known pathogenic mutation and a previously unreported mutation affecting splicing. Thus, cobalamin (cbl)G deficiency was diagnosed.
Peripheral blood smear analysis was key in this case, linking microangiopathic hemolytic anemia to a megaloblastic process. This combination of findings is described in pernicious anemia and inborn errors of cobalamin metabolism affecting homocysteine methylation and conversion to methionine, specifically the methylcobalamin deficiencies cblC-G and cblJ. Key considerations in management are betaine and hydroxycobalamin supplementation, as well as thromboprophylaxis for intravascular coagulation attributable to markedly elevated homocysteine levels.
For additional images, visit the ASH IMAGE BANK, a reference and teaching tool that is continually updated with new atlas and case study images. For more information visit http://imagebank.hematology.org.
This feature is available to Subscribers Only
Sign In or Create an Account Close Modal